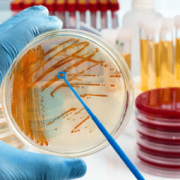
Cell Culture Products

Designed specifically for suppliers of commercial, pre-made catalog antibodies, this primary research report identifies scientists’ expectations and preferences with regards to usage, brands, purchasing, product quality and budgets. For companies competing in the antibodies market and for those about to enter, key findings highlight market share, competitive positioning, customer satisfaction and how well current products […]
November 2021 | BioInformatics Inc.